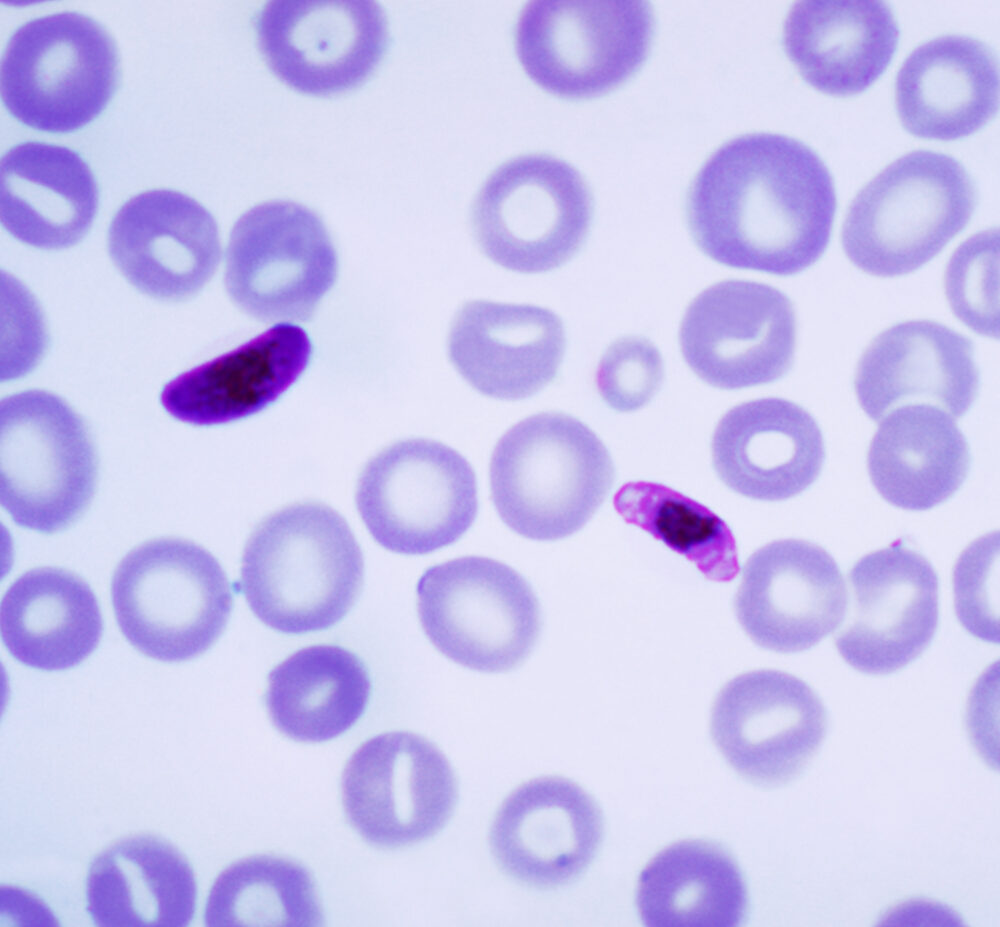

A l'écoute et rompus à la tâche pour votre bien-être
Fiables, rapides et confidentiels pour votre santé et celle de vos proches..

Pourquoi choisir notre laboratoire pour vos analyses biomédicales?
Grâce à une équipe de professionnels expérimentés, des équipements modernes, une démarche qualité rigoureuse avec plusieurs domaines d'intervention tels que la Biochimie, l'Hématologie, la Sérologie, la Microbiologie, etc... et la possibilité de Prélèvements à domicile, BioPharmed Diagnostic s’engage à vous offrir un service de santé fiable, humain et à proximité. Découvrez notre laboratoire biomédical au Bénin.
Nos spécialités biomédicales
Bactériologie
La bactériologie permet d'identifier les bactéries responsables d’infections afin d’assurer un traitement adapté et efficace.
Biochimie
La biochimie médicale évalue les fonctions vitales des organes pour détecter précocement les déséquilibres biologiques.
Biologie Moléculaire
La biologie moléculaire permet de détecter l’ADN ou l’ARN des agents pathogènes pour un diagnostic rapide et bien ciblé.
Hématologie
L’hématologie analyse les cellules sanguines pour diagnostiquer anémies, infections, leucémies et troubles de la coagulation.
Immuno-Hormonologie
L’immuno-hormonologie mesure les hormones et marqueurs immunitaires pour surveiller la fertilité, la thyroïde et bien plus.
Mycologie
La mycologie identifie les champignons pathogènes responsables d’infections cutanées, vaginales ou systémiques.
Parasitologie
La parasitologie détecte les parasites intestinaux, sanguins ou urinaires pour diagnostiquer paludisme, amibiase, oxyurose, etc.
Virologie
La virologie analyse la présence de virus comme le VIH, l’hépatite, la dengue, ou la grippe pour une prise en charge rapide.
Nous proposons 100+ Analyses de Biologie Médicale. En savoir plus sur nos analyses médicales à Calavi. Vous pouvez également prendre rendez-vous au laboratoire maintenant si vous désirez rencontrer un de nos spécialistes.
Prenez votre rendez-vous ici !
Une équipe de professionnels qualifiés en biologie médicale
Ce que nos clients pensent de nous




Service diligent
Propreté des lieux
Ecoute des patients






Nos Nouvelles et conseils santé
Nos Partenaires